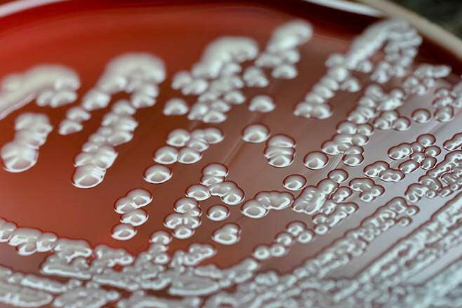

2016-2022 All Rights Reserved.平安財經網.復制必究 聯系QQ 備案號:
本站除標明“本站原創”外所有信息均轉載自互聯網 版權歸原作者所有。
郵箱:toplearningteam#gmail.com (請將#換成@)
如果您必須根據當天的胃感或最近的洗手間所在的位置來計劃郊游,該怎么辦?對于許多患有炎癥性腸病(IBD)的人來說,其膽量會對他們的日常生活質量產生過大的影響。
IBD最常見的一種形式稱為克羅恩氏病,其特征是消化道內發炎,可導致嚴重的腹瀉,疼痛和體重減輕。導致IBD的原因仍然是個謎,但科學家現在知道,腸道微生物組是關鍵分子,腸道微生物組由在腸道內形成家的數萬億細菌組成。
在《自然微生物學》(Nature Microbiology)上的一篇新論文中,密歇根州的醫學研究人員描述了不良細菌如何比IBD 更好的細菌獲得立足之地,以及簡單的飲食改變如何就能逆轉它。內科醫學部消化內科的內田信彥說:“健康和發炎的消化道中也存在同樣的細菌。” “他們只是改變了競爭。我們想知道背后的機制是什么?”
盡管正常食物中存在著許多食物中毒背后的臭名昭著的細菌大腸桿菌,但是當腸道發炎時,這種致病性細菌可以勝過其良性表親。在密歇根微生物組項目的早期工作中,Kamada的團隊表明,劣質大腸桿菌通常通過碳水化合物的代謝而受到良好的大腸桿菌和其他有益細菌的控制,碳水化合物是大腸桿菌首選的養分來源。然而,在發炎的情況下,良好細菌種類的數量減少了,留下的可用糖較少,可供大腸桿菌使用和生長。然而,致病的大腸桿菌 仍然能夠接管。
研究小組假設,不良大腸桿菌必須將飲食偏好從糖改為其他,使其比其他細菌更具優勢。實際上,他們對小鼠模型的實驗發現,當環境發炎時,不良大腸桿菌會產生一種氨基酸的味道,尤其是絲氨酸。Kamada實驗室的研究員Sho Kitamoto博士說:“我們發現,致病的大腸桿菌已上調了絲氨酸代謝的基因。” 此外,該團隊還可以通過給IBD小鼠喂低絲氨酸飲食來控制過度生長。
這些發現共同暗示了通過營養控制有害細菌的可能機制。Kamada說:“當然,我們可以使用抗生素殺死有害細菌。” “但是腸道菌群對宿主生物學起著有益的作用,抗生素會殺死好人和壞人。”
他們希望最終與臨床醫生合作,研究個性化治療飲食對IBD患者的影響。Kamada說:“我們必須仔細考慮患者的疾病狀況。一種飲食可能對緩解期患者有效,但對活動性疾病患者無效。”
2016-2022 All Rights Reserved.平安財經網.復制必究 聯系QQ 備案號:
本站除標明“本站原創”外所有信息均轉載自互聯網 版權歸原作者所有。
郵箱:toplearningteam#gmail.com (請將#換成@)